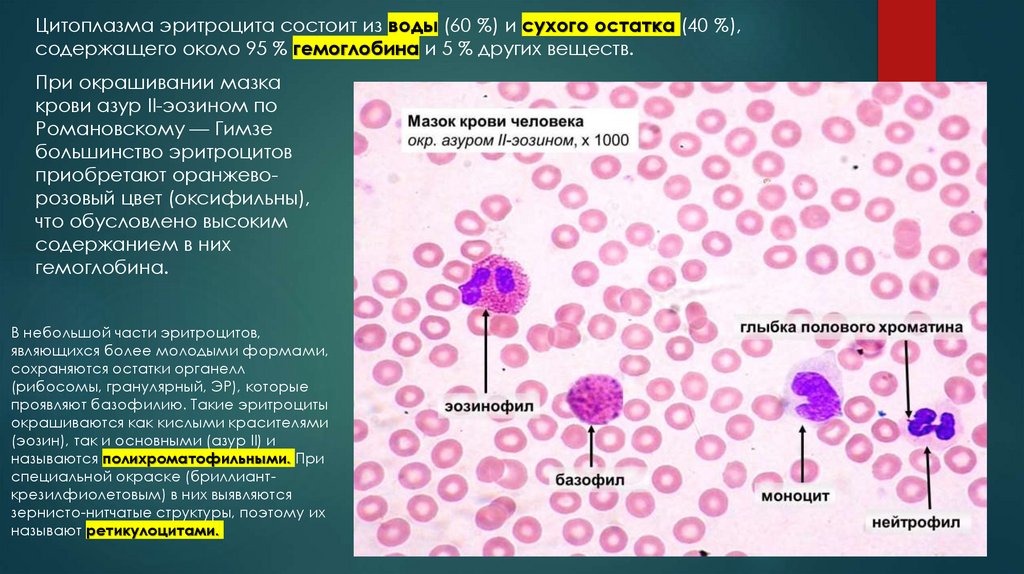
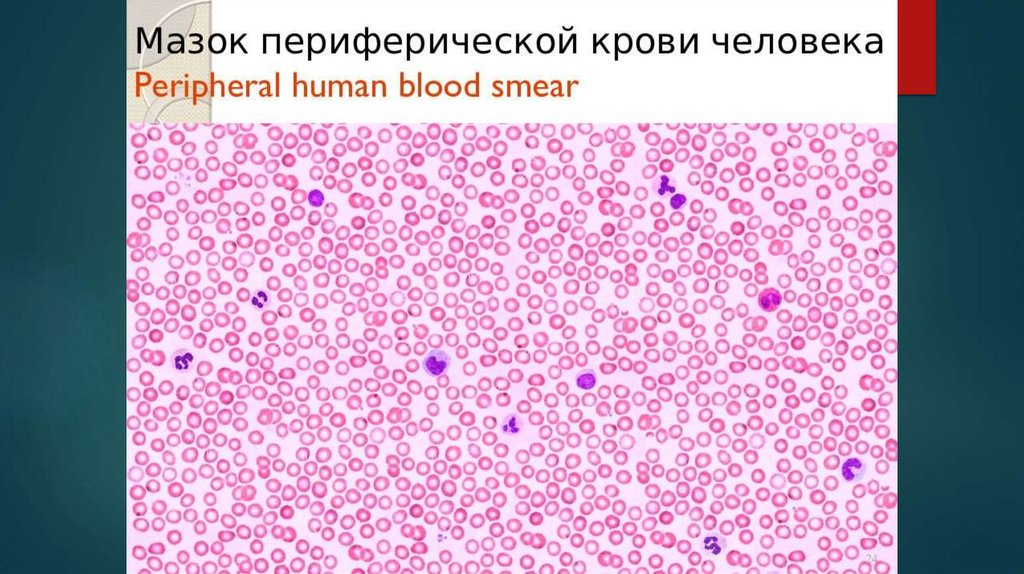

Similar presentations:
Ткани внутренней среды. Лабораторная работа 4-6
1. Ткани внутренней среды
ЛАБОРАТОРНАЯ РАБОТА 4-62.
К тканям внутренней среды организма относятся:а) кровь и лимфа;
б) кроветворные ткани (миелоидная и лимфоидная);
в) собственно соединительные ткани;
г) соединительные ткани со специальными свойствами (ретикулярная, жировая, слизистая);
д) скелетные соединительные ткани (хрящевые и костные).
Кровь
Микроциркуляторное русло
3.
Кроветворные тканиМиелоидная ткань
Лимфоидная ткань
4.
Собственно соединительные тканиПлотная волокнистая с.тк.
Рыхлая волокнистая с.тк.
5.
Соединительные ткани со специальными свойствамиЖировая
Ретикулярная ткань
Пигментная ткань
6.
Скелетные тканиХрящевая ткань
Костная ткань
7.
Хорошо развитомежклеточное
вещество
Происходят из
мезенхимы
Выполняют функции:
трофическая и защитная;
Механическая и опорная.
8.
Препарат №1. Мезенхима зародыша свиньи.Окраска гематоксилин-эозином
Совокупность эмбриональных сетевидно связанных отростчатых клеток,
заполняющих промежутки между более компактными эпителиоподобными
зародышевыми листками и зачатками органов.
Развивается из всех трех зародышевых листков
Является источником развития тканей
внутренней среды
Рассмотреть препарат на малом
увеличении.
Перевести на большое увеличение,
рассмотреть препарат. Обратить
внимание на отростчатые клетки
мехенхимы, образующие
функциональный синцитий.
Зарисовать и обозначить:
1. Клетки мезенхимы;
2. Ядра;
3. Ядрышки;
4. Отростки.
9. Кровь и лимфа. Кроветворение
10.
Система кровиКровь
Органы кроветворения
Красный костный мозг;
Тимус;
Селезенка;
Лимфатические узлы;
Лимфоидная ткань некроветворных органов
11.
Элементы кровиИмеют общее происхождение
Из мезенхимы
Общие структурнофункциональные
особенности
Тесно взаимодействуют
друг с другом
Подчинятся общим законам
нейрогуморальной
регуляции
12.
Кровь – жидкая ткань организмаЦиркулирует в сердечно-сосудистой системе.
Составляет 5-9% массы тела (5-5,5 л).
Функции крови
Защитная
Гуморальный и клеточный иммунитет
Гомеостатическая
Транспортная
Дыхательная
О2, СО2
Гуморальная
Трофическая
Доставка питательных веществ
Выделительная
Удаление продуктов обмена
Транспорт гормонов и БАВ
Поддержание гомеостаза
13.
Белки плазмы (альбумины, глобулины, фибриноген).Онкотическое давление;
Иммунные белки (антитела) – иммуноглобулины (Ig); фракция
Плазма (55%);
Форменные элементы (45%). глобулинов (γ);
Альбумины переносят различных веществ (СЖК, билирубин и др.)
Фибриноген принимает участие в процессах свертывания крови
Кровь состоит из:
Плазма крови – жидкая
составная крови,
содержит:
90-92% воды;
10% сухого остатка:
1,5-3,5% органические и
минеральные соли;
6,6-8,5% белки:
Альбумины;
Глобулины;
Фибриноген.
14.
Приготовление мазка кровиФорменные элементы крови
Эритроциты;
Лейкоциты;
Кровяные пластинки.
15.
ЭритроцитыКрасные кровяные тельца
Безъядерные клетки
Высокодифференцированные
постклеточные структуры
Утратили ядро и
органеллы в процессе
фило- и онтогенеза
Неспособны к делению
Количество эритроцитов у взрослого
мужчины составляет 3,9-5,5 • 10*12 л, а у
женщин - 3,7-4,9 • 10*12/л крови
Варьирует в зависимости от:
• Возраста;
• Эмоциональной нагрузки;
• Мышечной нагрузки;
• Экологических факторов.
Функция (основная)
дыхательная
Перенос О2 и СО2
Переносят:
• Аминокислоты;
• Токсины;
• Антитела;
• Лекарственные вещества
16.
Форма эритроцитовДискоциты
Планоциты
Двояковогнутый диски Плоская
80-90%
поверхность
Стареющие формы
Эхиноциты
Шиповидные
6%
Стоматоциты
Сфероциты
Куполообразные Шарообразные
1-3%
1%
микросфероциты
17.
Нормальные и патологические формы эритроцитовДискоциты (норма)
планоциты (с плоской
поверхностью);
Стареющие:
эхиноциты (-6 %),
стоматоциты (-1—3 %),
сфероциты (-1 %)
Процесс старения
эритроцитов идет двумя
путями - кренированием
(образование зубцов на
плазмолемме) или путем
инвагинации участков
плазмолеммы
18.
Нормальные и патологические формы эритроцитовПри заболеваниях могут появляться аномальные формы эритроцитов, что чаще всего обусловлено
изменением структуры гемоглобина (НЬ). Замена даже одной аминокислоты в молекуле НЬ может
быть причиной изменения формы эритроцитов. В качестве примера можно привести появление
эритроцитов серповидной формы при серповидно-клеточной анемии, когда у больного имеет место
генетическое повреждение в p-цепи гемоглобина.
Процесс нарушения формы эритроцитов при заболеваниях получил название п о й к и л о ц и т о з .
19.
Гемолиз эритроцитовгемолиз сопровождается выхождением
гемоглобина; при этом в крови обнаруживаются
"тени" (оболочки) эритроцитов
Обязательной составной частью
популяции эритроцитов являются их
молодые формы (1-5 %),
называемые ретикулоцитами, или
полихроматофильными
эритроцитами .
20.
Цитоскелет эритроцитовПлазмолемма эритроцита состоит из бислоя липидов и белков, представленных
приблизительно в равных количествах, а также не большого количества углеводов,
формирующих гликокаликс.
Белки цитоскелета:
Спектрин (основной белок цитоскелета);
Актин;
Анкирин (связывает спектрин).
Полоса 3 (транспорт газов)
«Узловой комплекс»:
Спектрин, белок полосы 4.1,
актин, гликофорин
поддерживает форму
эритроцита и противостоит
давлению при
прохождении его через
тонкий капилляр
гликофорины (с ними связывают антигенные различия между группами крови человека)
Наличие агглютиногенов (А и В)
21.
Группы кровиВ крови 0(I) группы отсутствуют
агглютиногены А и В, но
имеются α- и β-агглютинины;
в крови А(II) группы имеются
агглютиноген А и β-агглютинин;
в крови В(III) группы содержатся
В-агглютиноген и а-агглютинин;
в крови AB(IV) группы имеют
ся агглютиногены А и В и нет
агглютининов.
На поверхности эритроцитов
имеется также резус-фактор
(Rh-фактор) — агглютиноген.
Он присутствует у 86 % людей;
у 14 % отсутствует (резусотрицательные).
22.
Агглютинация эритроцитов свойственна нормальной свежей крови, при этом образуются такназываемые «монетные» столбики. Это явление связано с потерей заряда плазмолеммы
эритроцитов.
23.
Цитоплазма эритроцита состоит из воды (60 %) и сухого остатка (40 %),содержащего около 95 % гемоглобина и 5 % других веществ.
При окрашивании мазка
крови азур II-эозином по
Романовскому — Гимзе
большинство эритроцитов
приобретают оранжеворозовый цвет (оксифильны),
что обусловлено высоким
содержанием в них
гемоглобина.
В небольшой части эритроцитов,
являющихся более молодыми формами,
сохраняются остатки органелл
(рибосомы, гранулярный, ЭР), которые
проявляют базофилию. Такие эритроциты
окрашиваются как кислыми красителями
(эозин), так и основными (азур II) и
называются полихроматофильными. При
специальной окраске (бриллианткрезилфиолетовым) в них выявляются
зернисто-нитчатые структуры, поэтому их
называют ретикулоцитами.
24.
ГемоглобинГемоглобин - это сложный белок, состоящий из 4
полипептидных цепей глобина и гема
(железосодержащий порфирин), обладающий
высокой способностью связывать кислород. В
норме у человека содержится два типа
гемоглобина - НЬА и HbF.
Железо (Fe2+) в геме может присоединять 02 в
легких (в таких случаях образуется оксигемоглобин
- НЬ02) и отдавать его в тканях путем диссоциации
НЬ02 на кислород ( 02) и НЬ; валентность Fe2* не
изменяется.
В тканях выделяемая С02 поступает в эритроциты и
соединяется с НЬ, образуя карбоксигемоглобин.
25.
Гемолиз эритроцитовСтарые эритроциты
разрушаются макрофагами
главным образом в селезенке, а
также в печени и костном мозге,
при этом НЬ распадается, а
высвобождающееся из
железосодержащего гема
железо используется для
образования новых эритроцитов.
Средняя продолжи
тельность жизни эритроцитов
составляет около 120 дней.
26.
Лейкоциты4-9 • 10*9/л
белые кровяные клетки
Зернистые
(гранулоциты)
при окраске крови смесью кислого (эозин) и
основного (азур И) красителей в цитоплазме
выявляются специфическая зернистость и
сегментированные ядра; образуются в красном
костном мозге
нейтрофилы
эозинофилы
Незернистые
(агранулоциты)
характеризуется отсутствием
специфической зернистости и
несегментированными ядрами
базофилы
Лейкоциты способны к активному перемещению путем
образования псевдоподий, при этом у них изменяются
форма тела и ядра. Направление движения лейкоцитов
определяется хемотаксисом под влиянием химических
раздражителей. Лейкоциты выполняют защитные функции,
обеспечивая фагоцитоз, участвуя в иммунных реакциях
27.
Самая многочисленнаягруппа лейкоцитов
Нейтрофильные гранулоциты
Для женщин характерно наличие в ряде
нейтрофилов полового хроматина (Ххромосома) в виде барабанной палочки тельца Барра.
диаметр в мазке крови 10-12 мкм,
а в капле свежей крови 7-9 мкм.
В зрелом нейтрофиле ядро содержит 3-5 сегментов,
соединенных тонкими перемычками.
• Юные (0-0,5%) ядро бобовидное.
• Палочкоядерные (1-6%) несегментированное ядро в форме S, изогнутой
палочки, подковы. Воспалительные процессы и кровопотери.
• Сегментоядерные зрелый.
28.
Нейтрофильные гранулоцитыЦитоплазма нейтрофилов при окраске по Романовскому-Гимзе окрашивается
слабооксифильно, в ней видна очень мелкая зернистость розово-фиолетового цвета
(окрашивается кислыми и основными красками), поэтому называется нейтрофильной или
гетерофильной. В поверхностном слое цитоплазмы зернистость и органеллы отсутствуют.
В поверхностном слое цитоплазмы
расположены гранулы гликогена,
актиновые филаменты и микротрубочки
Во внутренней части цитоплазмы
расположены органеллы, видна зернистость.
Специфические гранулы, более светлые,
мелкие и многочисленные; содержат
бактериостатические и бактерицидные
вещества (лизоцим, щелочную
фосфатазу, белок лактоферрин)
Азурофильные гранулы более крупные,
окрашиваются в фиолетово-красный цвет;
их количество составляет 10-20 % всей
популяции гранул; содержат
лизосомальные ферменты.
29.
Нейтрофилы фагоцитируют и разрушают бактерииРаспознавание
рецепторами бактерии
Эндоцитоз
Слияние с лизосомами
(азурофильные гранулы) +
специфические гранулы
Разрушение бактерии
Образуются свободные формы
кислорода, перекись водорода
Взрыв
(гибель нейтрофила и бактерии)
Гной
микрофаги
30.
Эозинофильные гранулоцитыЯдро имеет 2 сегмента, соединенных перемычкой
Гранулы:
• азурофильные (первичные)
• эозинофильные (вторичные)
Специфическая
функция антипаразиратная
Антиаллергическое действие
Способны к
фагоцитозу;
Подвижны
В цитоплазме расположены органеллы – АГ,
немногочисленные митохондрии, актиновые
филаменты под плазмолеммой и гранулы.
31.
Гранулы эозинофилаЯвляются модифицированными лизосомами
Содержат гидролитические ферменты
Содержат основной белок, гистаминазу, пероксидазу, эозинофильный катионный белок
Кристаллоид имеет пластинчатое
строение – главный основной белок
(антипаразитарная функция)
32.
Участие эозинофилов в аллергических реакцияхФагоцитируют
гистаминсодержащие гранулы;
Разрушают гистамин
(гистаминазой);
Тормозят освобождение гистамина.
33.
Базофильные гранулоцитыЯдра содержат 2-3 сегмента
• Опосредуют воспаление;
• Вырабатывает эозинофильный
хемотаксический фактор;
• Участвую в регуляции
процессов свертывания крови
и проницаемости сосудов;
• Участвуют в аллергических
реакциях.
Гранулы содержат гистамин и гепарин
Модифицированные лизосомы
34.
Агранулоциты (незернистые лейкоциты)• Не содержат гранул;
• Ядра несегментированы.
Моноциты
Лимфоциты
Т
В
35.
Выделяют:Большие (юные);
Средние;
Малые.
Лимфоциты
Т-лимфоциты
(тимусзависимые)
В-лимфоциты
36.
МоноцитыПредшественники всех макрофагов
Самые крупные клетки крови (в мазве до 20 мкм)
Ядро изменчивой формы
Мононуклеарная фагоцитарная
система (МФС)
На периферии окрашивается более ярок - лизосомы
37.
Лейкоцитарная формула% соотношение лейкоцитов крови
Нейтрофилы – 60-75%
Лимфоциты – 20-35%
Моноциты – 6-8%
Эозинофилы – 0,5-5%
Базофилы – 0,5-1%
38.
Лейкоциты39.
Тромбоциты (кровяные пластинки)Мелкие бесцветные округлые, овальные или ветеретеновидные тельца
Безъядерные фрагменты – обломки мегакариоцитов
Двояковыпуклые диски
В гранулах факторы
свертывания крови
(тромбопластин)
Гиаломер – светлая часть
Грануломер – темная часть
40.
Образование тромбаАгрегация пластинок
Образование нитей фибрина
Прилипание к нитям фибрина
Образование тромба
Ретракция
41.
ЛимфаЖелтоватая жидкость, белковой природы, протекающая в лимфатических сосудах
Лимфоплазма
Близка к плазме крови,
но беднее на белки
Форменные элементы
Лимфоциты + моноциты
42.
ГемопоэзОбразование форменных
элементов крови
Эмбриональный – образование крови как ткани
Постэмбриональный – процесс восстановления (регенерации) крови
43.
Схема кроветворения44.
Препарат №2. Мазок крови человека. Окраска по Романовскому –ГимзеНа препарате основная часть форменных элементов крови представлена эритроцитами
(которых примерно в 1000 раз больше, чем лейкоцитов).
Зарисовать мазок крови.
Обозначить форменные
элементы крови.
45.
46. Собственно соединительные ткани
Волокнистые соединительные ткани и соединительные ткани соспециальными свойствами
47.
Соединительные ткани - это комплекс мезенхимных производных, состоящий из клеточныхдифферонов и большого количества межклеточного вещества (волокнистых структур и
аморфного вещества), участвующих в поддержании гомеостаза внутренней среды и
отличающихся от других тканей меньшей потребностью в аэробных окислительных процессах.
Соединительная ткань составляет
более 50 % массы тела человека.
Полифункциональный
характер соединительных
тканей определяется
сложностью их состава и
организации.
Функции соединительных тканей:
трофическая (участие в обмене веществ и поддержании гомеостаза);
защитная (механическая защита; фагоцитоз, выработка антител);
опорная (биомеханическую);
формообразующая (образуют каркас, строму органов);
пластическая (заживление ран).
48.
Волокнистый соединительные ткани49.
Главными компонентами соединительных тканей являются:производные клеток: волокнистые структуры коллагенового и эластического типов;
основное (аморфное) вещество, играющее роль интегративно-буферной метаболической
среды
клеточные элементы, создающие и поддерживающие количественное и качественное
соотношение состава неклеточных компонентов.
50.
Основными клеткамисоединительной ткани являются:
• фибробласты (семейство
фибриллообразующих клеток);
• макрофаги (семейство);
• тучные клетки;
• адвентициальные клетки;
• плазматические клетки;
• перициты;
• жировые клетки;
• лейкоциты, мигрирующие из
крови;
• иногда пигментные клетки.
Межклеточное вещество
образуется:
• путем секреции, осуществляемой
соединительнотканными
клетками;
• из плазмы крови, поступающей в
межклеточные пространства.
В течение жизни межклеточное вещество
постоянно обновляется: резорбируется и
восстанавливается.
51.
Рыхлая волокнистая соединительная тканьОбнаруживается во всех органах, сопровождает
кровеносные и лимфатические сосуды и образует
строму многих органов.
Содержит до 10 типов клеток,
коллагеновые и эластические волокна
(рыхло расположены), много
аморфного вещества
вездесущая
52.
ФибробластыОсновная клетка РВСТ.
Функции:
Образует межклеточное вещество (б. волокон (коллаген
и эластин) и аморфного вещества (протеогликаны,
гликопротеины);
Заживление ран;
Развитие рубцевой ткани.
Обладает высокой биосинтетической активностью
Ядро светлое, овальное, 1-2
ядрышка;
Цитоплазма базофильна,
хорошо развиты ЭПС и АГ;
Митохондрии и лизосомы
развиты умерено.
Имеет хорошо выраженную ЭПС и АГ
Микрофиламенты (актин и миозин)
движение
53.
ФибробластыСтволовая клетка
Малоспециализированная клетка
Фибробласт
Фиброцит
Миофибробласт,
липофибробласт,
фиброкласт
Малодифференцированный
Фиброцит
54.
Макрофаги (гистиоциты)Имеют четкие, неровные границы, образуют складки и микровыросты.
Свободно перемещаются
Яра небольшие, одиночные, окргулые/ бобовидные/
неправильной формы, содержат большие глыбки хроматина
Цитоплазма базофильна, содержит лизосомы, фагосомы,
пиноцитозные пузырьки; митоходнрии, ЭПС, АГ, гликоген
липиды – умерено.
«Клеточная периферия» – передвижение + актиновые
филаменты – движение везикул, лизосом.
На поверхности рецепторный аппарат.
Функции:
Поглощение, расщепление, «представление» антигенов;
Выработка БАВ.
Воспалительный процесс
количество М.
«Многоядерные гигантские
клетки» (симпласты)
55.
Плазматические клетки (плазмоциты)Потомки В-лимфоцитов
Форма округлая/овальная
Патоген
выработка антител
количество плазмоцитов
Ядра небольшие, округлые/овальные,
эксцентрично
Цитоплазма базофильна, хорошо
развиты ЭПС и «светлые дворики» - АГ
56.
Тучные клетки (тканевые базофилы)Функции:
Свертывание крови;
Проницаемость гематотканевого
барьера в процессе воспаления.
Выброс гранул
патоген
изменение тк. гомеостаза
Специфичная зернистость
Форма разнообразна.
Ядра небольшие округлые/овальные.
В цитоплазме многочисленные гранулы
(гепарин, гиалуроновая кислота, гистамин).
57.
Накапливают капли жира;Участвуют в трофике;
Энергообмен;
Метаболизм воды.
Адипоциты (жировые клетки)
Мелкие капли жира
А. округлой формы, в центре
капля жира, ядро,
немногочисленные митохондрии
1 большая капля
Скопление адипоцитов – жировая ткань
ЭПС, АГ редуцируются;
Ядра смещаются.
58.
Адвентициальная клеткаМалоспециализированная клетка;
Расположены по ходу сосудов
Перициты
фибробласты
миофибробласты
адипоциты
Окружают сосуд
Пигментоциты
Содержат пигмент – меланин (в меланосомах);
Имеют отростки, нейрональное происхождение
(не соед. тк.);
Вырабатывают амины
регуляция тонуса
сосудов.
59.
Клетки рыхлой волокнистой соединительной ткани60.
Межклеточное веществоВолокна
Коллагеновые
Эластические
Аморфный компонент
Межкл. В-во образуется
Секреция соед.тк.
Из плазмы крови
61.
ВолокнаОриентированные
Неориентированные
Смешанные
Оформленные
Неоформленные
Роговица, склера
Сухожилия, связки,
фасции и т.д.
Дерма
62.
Коллагеновые волокнаКоллаген
В клетке
тропоколлаген
14 видов
микрофибриллы
Синтезируют фибробласты
фибриллы
волокна
Вне клетки
Обеспечивают прочность на
разрыв, с малой
растяжимостью.
Разновидность ретикулярные
волокна (ретикулум)
63.
Эластические волокнаМикрофибриллярный компонент
Аморфный компонент
Анастамозируют
Основа эластин + пролин, глицин,
десмин и изодесмин (стабилизация Э.)
Глобулы
В клетке
протофибриллы
микрофибриллы
Вне клетки
волокна
Прочность ниже к.в-н;
Эластичность и
растяжимость
64.
Аморфный компонент межклеточного веществаГелеобразная субстанция
Многокомпонентная среда, окружающая
клеточные и волокнистые структуры соед.тк.,
нервные и сосудистые элементы
Состав:
Белки плазмы крови;
Вода;
Неорганические ионы;
Продукты метаболизма;
Расворимые предшественники К. и Э.;
Протеогликаны;
Гликозаминогликаны (гиалуроновая
кислота)
Гликопротеины.
65.
Препарат №1. Пленочный препарат – рыхлая волокнистаянеоформленная соединительная ткань. Окраска гематоксилином
На малом увеличении найти
светлый участок.
На большом увеличении
рассмотреть, зарисовать и
обозначить:
66.
Препарат №1. Пленочный препарат – рыхлая волокнистаянеоформленная соединительная ткань. Окраска гематоксилином
67.
Плотная волокнистая соединительная тканьБольшое количество волокон и небольшое – клеток и аморфного вещества.
Волокна
оформленная (упорядоченно)
неоформленная (неупорядоченно)
Выйная связка – эластические в-на
68.
Препарат №2. Плотная волокнистая оформленная соединительнаяткань сухожилия. Окраска гематоксилин-эозином
69.
Препарат №2. Плотная волокнистая оформленная соединительнаяткань сухожилия. Окраска гематоксилин-эозином
Зарисовать и обозначит:
70.
Препарат №3. Плотная волокнистая оформленная соединительнаяткань связки. Окраска пикрофуксин и гематоксилин
1. Эластические волокна
2. Фиброциты
71.
Препарат №4. Плотная волокнистая неоформленнаясоединительная ткань кожи пальца. Окраска гематоксилинэозином
Зарисовать и обозначит:
1. Эпидермис
2. ПВСТ (неоформленная)
3. Жировая ткань
72.
Препарат №5. Ретикулярные волокна (ретикулярная ткань)лимфатического узла. Окраска гематоксилин-эозином
Включает ретикулоциты и ретикулярные волокна
Импрегнация нитратом
серебра
73.
Препарат №6. Белая жировая ткань (тотальный препаратсальника). Окраска гематоксилин и суданом III
Зарисовать и обозначит:
1. Цитоплазма адипоцита
2. Ядро алипоцита
74.
Препарат №7. Бурая жировая ткань новорожденного. Окраскагематоксилин-эозином
Зарисовать и обозначит:
1. Адипоцит;
2. Ядра адипоцитов;
3. Кровеносные капилляры.
75. Скелетные ткани
ХРЯЩЕВЫЕ И КОСТНЫЕ76.
Скелетные тканиОпорная, защитная (механическая) функции
Плотное межклеточное вещество
Водно-солевой
обмен веществ
Относят:
Хрящевые ткани;
Костные ткани;
Дентин;
Цемент зуба
77.
Хрящевые тканиклетки: стволовые, полустволовые,
хондробласты, хондроциты
В свежей хрящевой ткани 70-80% воды, 1015% органических веществ, 4-7% солей.
Входит в состав органов
дыхания, суставов,
межпозвоночных дисков
До 70% сухого вещества приходится на коллаген
Тургор
Не имеет
кровеносных
сосудов
Вещества
диффундируют из
надхрящницы
78.
Классификация хрящевой тканиВ зависимости от содержания и соотношения эластических и коллагеновых волокон
Гиалиновая
Эластическая
Волокнистая
79.
Классификация хрящевой ткани80.
Хрящевой дифферонРазвитие из мезенхимы
Стволовая клетка
Предположительно
округлой формы,
высокое ядерноцитоплазматическое
отношение,
диффузное
расположение
хроматина и
небольшое ядрышко;
органеллы развиты
слабо
полустволовая (прехондробласты)
Клетка удлиненной
формы; больше рибосом
(чем в СК), ЭПС,
уменьшается ядерноцитоплазматическое
отношение
Невысокая пролиферативная активность
хондробласты (хондробластоциты)
Молодые, уплощенные клетки;
способны к пролиферации и
синтезу протеогликанов
(межклеточное вещество);
Хондроциты
содержит грЭПС, АГ;
Изогенные
проявляют базофильность
группы
(РНК).
Клетки овальной, округлой,
полигональной формы.
1 типа
(репродукция
изогенных групп)
2 типа (протеогликан и
гликозаминогликан)
3 тип синтез белка
81.
Эмбриональный хондрогистогенезКлетки остеогенной мезенхимы утрачивают
отростки, группируются и образуют напряжение
- тургор
Хондрогенные зачатки или хондрогенные
островки
Хондробласты синтезируют и секретируют
коллаген + периферический рост хряща
Хондроциты формируют изогенные группы
(внутренний (интерстициальный) рост)
82.
Гиалиновый хрящ1. Наиболее распространенный вид хрящевой ткани;
2. Покрыт надхрящницей (2 слоя);
3. Клетки образуют изогенные группы (2-4 хондроцита);
4. Хондронектин – соединяет клетки между собой + с субстратом
5. В хряще выделяют зоны: поверхностная, промежуточная, глубокая;
6. Гликозаминогликаны, протеогликаны.
83.
Препарат №1. Гиалиновый хрящ ребра кролика. Окраскагематоксилин-эозин
При малом увеличении видна надхрящница и лежащая под ней
хрящевая ткань. Причем ближе к надхрящнице лежит слой молодого
хряща, а затем зрелая хрящевая ткань.
При большом увеличении можно увидеть, что в состав
промежуточного вещества надхрящницы входят коллагеновые волокна,
фибробласты. В надхрящнице и в молодом слое хряща большое
количество хондробластов, а в промежуточном веществе хряща, в
результате пролиферации, хондроциты располагаются изогенными
группами. Межклеточное вещество окрашивается: территориальный
матрикс – базофильно, интерриториальный матрикс окрашивается
слабо базофильно или слабо оксифильно.
Зарисовать и обозначить:
84.
Эластический хрящ1. Встречается в ушных раковинах;
2. Желтоватого цвета;
3. Хондробласты+хондроциты;
4. Эластические волокна в межклеточном веществе;
5. Надкостница.
85.
Препарат №2. Эластический хрящ ушной раковиныВ состав эластического хряща, кроме коллагеновых волокон,
свиньи. Окраска орсеин
входит большое количество эластических волокон, которые
образуют густую сеть. На периферии хрящевой пластинки
волокна более тонкие и ветвящиеся, к центру они утолщаются.
Основной матрикс окрашен в светло-коричневый цвет (орсеин).
Как и в гиалиновом хряще, в эластическом содержатся
изогенные группы, однако в них содержится меньшее число
хондроцитов, обычно 2-3 и они крупнее.
Зарисовать и
обозначить:
1. Надкостница;
2. Эластические
волокна;
3. Изогенные
группы;
4. Хондроциты.
86.
Препарат №3. Волокнистый хрящ межпозвоночного дискателенка. Окраска гематоксилин-эозин
При большом увеличении можно рассмотреть, что основное вещество - коллагеновые волокна,
ориентированные в одном направлении. Между пучками коллагеновых волокон располагаются тонкие
прослойки гиалинового хряща, с расположенными в нем одиночными или небольшими изогенными
группами хондроцитов. Волокнистый хрящ представляет собой промежуточное положение между
сухожилием и гиалиновым хрящом. Поэтому, передвигая препарат можно увидеть переходы между этими
тканями. В гиалиновом хряще коллагеновые волокна располагаются отдельными группами, затем их
становится больше и, постепенно утолщаясь, они вытесняют гомогенное вещество.
Зарисовать и обозначить:
1 - пучки коллагеновых волокон;
2 - хрящевые клетки между пучками волокон
87.
Функции:Костная ткань
- Образует скелет – опору тела;
- Защищает мозг, внутренние органы и костный мозг;
- Трофическая: депо солей кальция и фосфора.
88.
Костная тканьСостоит из:
- Клеток (остеоциты, остеобласты, остеокласты);
- Основного вещества, пропитанное солями;
- Коллагеновых волокон.
остеобласт
аморфные
гидроксиапатиты
Характерны постоянные адаптивные
перестройки
Дифферон
Остеогенная клетка
Более 70% минеральных веществ (соли)
остеоцит
89.
Остеобласты продуцируют компонентымежклеточного вещества и сами в нем себя
замуровывают
90.
ОстеобластХорошо развиты ЭПС, АГ;
Образуют компоненты аморфного
вещества;
Замуровывают себя в матриксе и
превращаются в остеоциты
91.
ОстеоцитыМало органелл;
Не продуцируют межклеточное
вещество;
Расположены в лакунах;
Имеют связь друг с другом (через
канальца).
92.
ОстеокластыРазрушают кость;
Гигантские многоядерные клетки;
Происходят из моноцитов крови;
Надклеточная структура - симпласт
93.
Остеокласты Прикрепляется к косной балке прозрачнойзоне;
Центральная часть – складчатая
(гофрированная зона), образует слабую
угольную кислоту
94.
Классификация костной тканиКомпактное вещество
Ретикулофиброзная
(грубоволокнистая)
Пластинчатая
Отличия связаны с межклеточным веществом
Коллагеновые беспорядочны
Швы черепа, область сухожилий
Губчатое вещество
95.
Препарат № 4. Ретикулофиброзная (грубоволокнистая) костная ткань. Тотальный плоскостныйпрепарат (не окрашен)
Зарисовать и обозначить:
1.Лакуна (место залегания остеоцита);
2. Костные канальца (место прохождения отростков);
3. Межклеточное вещество
96.
Пластинчатая костная тканьСостоит из костных пластинок;
Между пластинок расположены остеоциты;
Коллаген в соседних пластинках проходит неодинаково
Различают компактную и губчатую
97.
Пластинчатая костная тканьКомпактное – диафиз трубчатых костей;
Губчатое – эпифиз, плоские, губчатые кости
98.
Кость как орган- Надкостница;
- Слой наружных генеральных
пластинок;
- Остеоновый слой (остеоны +
вставочные пластинки);
- Слой внутренних общих
(генеральных) пластинок;
- Эндоост
Кровообращение
Сосуды образуют густую
сеть во внутреннем слое
надкостницы. Веточки сети
проникают в остеон и в
костный мозг
Диафиз трубчатой кости
99.
Остеон – Гаверсова системаСтруктурно-функциональная единица компактного вещества трубчатой кости
Костные пластинки, вставленные друг в друга;
Замурованные остеоциты и из отростки;
Спайная линия (цементирующая);
В центре кровеносный сосуд и остеогенные клетки
Связь между остеонами –
питательные (прободающие)
каналы
100.
Остеон – Гаверсова системаСтруктурно-функциональная единица компактного вещества трубчатой кости
101.
Препарат №5. пластинчатая костная ткань (поперечныйсрез декальцинированной трубчатой кости). Окраска по
методу Шморля
Зарисовать и обозначить:
1. Канал остеона:
1.1 Соед. тк.;
1.2 кровеносный сосуд;
2. Костные пластинки;
3. Лакуны с остеоцитами;
4 Костные канальца;
5. Периост
102.
Препарат №5. пластинчатая костная ткань (поперечный срездекальцинированной трубчатой кости). Окраска по методу Шморля
Зарисовать и обозначить:
1. Канал остеона:
1.1 Соед. тк.;
1.2 кровеносный сосуд;
2. Костные пластинки;
3. Лакуны с остеоцитами;
4 Костные канальца;
5. Периост
103.
Прямой остеогенезСтадия 1. образование
остеогенного островка;
Стадия 2. остеоидная стадия
(образование оксифильного
межклеточного вещества);
дифференцировка
остеобластов, замуровка,
образование остеоцитов +
аппозиционный рост;
Стадия 3. импрегнация
солями межклеточного
вещества (минерализация
межклеточного вещества);
образование периоста –
первичная губчатая кость;
Стадия 4. Замена вторичной
губчатой тканью (пластинчатая
костная ткань) – стадия
перестройки.
104.
Образование кости наместе соединительной
ткани (из мезенхимы).
Окраска гематоксилинэозин
Мезенхима
Остеобласты
Продукция межклеточного
вещества
Остеоциты
Минерализация
Костные балки
Образование
ретикулофиброзной ткани
Замена на пластинчатую
кость
Прямой остеогенез
105.
Хрящевая модельНепрямой остеогенез
Превращение надхрящницы в надкостницу
Нарушение питания хряща
Гибель хряща в этой области
Прорастание кровеносных сосудов в эту зону
Поступление моноцитов и остеобластов с кровью
Моноциты
остеобласты
Разрушение хряща
Образование костной ткани
Вторичные очаги окостенения
Образование костномозговой полости
Образование метафизарной пластинки роста
Пери- и эндохондральное окостенение
Замещение пластинки костной ткани (в 18-20лет)
106.
Непрямой остеогенез107.
Непрямой остеогенез108.
Регенерация костиПерелом
Размножение остеобластов надхрящницы
Образование грубоволокнистой костной ткани
Замещение на пластинчатую кость
Костная мозоль

biology
biology








